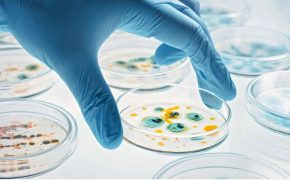

Akira Toriyama ha muerto, las redes sociales y los medios de comunicación han hecho foco de esta terrible noticia que enluta el mundo de la animación japonesa. El creador de series icónicas como Dragon Ball dejó un legado de éxitos y su trayectoria quedará para la historia.
El joven ilustrador quien en sus años de mayor actividad materializó sus sueños gracias a su trabajo duro e infinita creatividad, logró marcar la infancia de varias generaciones no solo las consecuentes con su época, sino también a las venideras.
Incluso personas famosas han lamentado el fallecimiento de Akira Toriyama, quién incluso se encontraba trabajando en nuevos proyectos que por el momento no se sabe si verán la luz o si serán delegados al olvido a causa de la partida física de su creador.
Pero, ¿Qué le pasó a Akira Toriyama? ¿De qué murió? El hecho de que el creador de Dragon Ball aún estuviera trabajando en nuevos proyectos refiere que no se encontraba en una fase crítica de su salud, o al menos eso era lo que se pensaba.
Descubre: Día de la mujer: 3 mujeres influyentes que cambiaron el mundo
¿Qué le pasó a Akira Toriyama?
Akira Toriyama ha fallecido a causa de complicaciones por un derrame cerebral, el japonés de 68 años no presentaba alguna enfermedad crónica o al menos eso era lo que se sabía antes de su muerte. Así que la noticia de su fallecimiento ha dejado perplejos a la mayoría.
Si bien tenía 68 años solía mantener unos hábitos bastante saludables, y también mantenía a buen ritmo sus trabajos creativos los cuales desafortunadamente ya no podrá ver en la gran pantalla. Los fans lloran y lamentan la partida física de este gran líder.
Durante más de 45 años Akira Toriyama fue partícipe del éxito de sus creaciones, y dejó un legado imborrable en la animación japonesa plantando un precedente para nuevas producciones. Hoy y siempre será reconocido como un pionero en este maravilloso mundo creativo.
Descubre: Rey Carlos III es diagnosticado con cáncer y ESTO se sabe
¿Quién fue Akira Toriyama?
Akira Toriyama nació en Japón en una ciudad llamada Nagoya en 1955, desde sus primeros años de edad se vio interesado por el dibujo y rápidamente mantuvo esa inclinación hasta abrir ese paso laboralmente.
Osamu Tezuka fue una de sus grandes inspiraciones y valoro mucho de sus trabajos en el manga japonés, rápidamente logró conseguir su propio sello o esencia dentro de la materialización de sus propias historias.
Su rol creativo dentro de Dragon Ball lo catapultó a la fama a nivel internacional, siendo hoy en día una leyenda absoluta en el mundo de la animación. Pero antes de eso también había cultivado un éxito con Dr. Slump entre 1980 y 1984.
|
Usa el comparador de seguros de hogar y obtén el mejor respaldo para la protección de tu casa. |
El mundo da adiós al creador de Dragón Ball
Incluso celebridades como actores o estrellas del fútbol han tomado algunos minutos de su tiempo para dedicar unas palabras de agradecimiento tras el fallecimiento de Akira Toriyama.
Se espera que las personas más allegadas a este genio de la animación japonesa le den su último adiós en las próximas horas, probablemente se rinda homenaje a quien tantas horas de sonrisas y entretenimiento ofreció a la juventud y al resto de las generaciones.

Hola, si desea colaborar con nosotros y poder vender seguros de todo tipo, entre todas las compañías con las que…